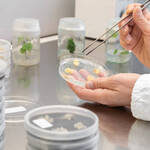
Image: cappa flusso orizzontale per coltura in vitro_3

L'approvazione della norma che autorizza la sperimentazione in campo delle produzioni ottenute mediante le tecniche di evoluzione assistita (TEA) rappresenta un risultato importante, perché le attività di ricerca già svolte nei laboratori hanno dimostrato risultati straordinari che ora possono passare “alla prova” in campo.
Le tecnologie di evoluzione assistita promettono di essere lo strumento chiave per aumentare la sostenibilità dei sistemi agricoli. Una sfida cruciale per la competitività del settore agroalimentare nazionale e per la ricerca scientifica del nostro paese: creare varietà resistenti ai patogeni, coltivabili con meno input chimici, in grado di fronteggiare gli effetti del cambiamento climatico, e al tempo stesso, soddisfare le richieste alimentari di una popolazione mondiale in crescita.
Il prof Mario Pezzotti, dirigente centro ricerca e innovazione, in merito all’approvazione dell’emendamento che autorizza la sperimentazione in campo delle TEA: "Finalmente e dopo molti anni di appassionati dibattiti con questo provvedimento si dimostra una piena condivisione di metodi e obiettivi fra comunità scientifica italiana, comunità dei produttori e decisori politici per un'innovazione in agricoltura italiana che, pur nel rispetto delle sue tradizioni, ci può portare verso un sistema produttivi che combini la sostenibilità ambientale, economica e sociale".